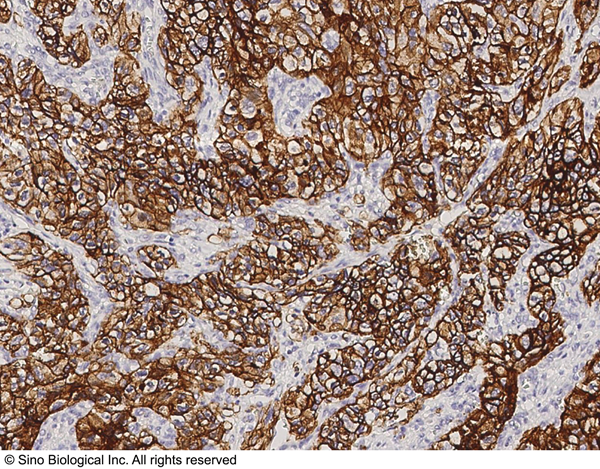
product-image-AAA258747_IHC13.png

Human Carbonic Anhydrase IX CLIA Kit | CA9 clia kit
Carbonic Anhydrase IX (Human) LumiAb ELISA Kit
Gene Names
CA9; MN; CAIX
Reactivity
Human
Synonyms
Carbonic Anhydrase IX; N/A; Carbonic Anhydrase IX (Human) LumiAb ELISA Kit; Human Carbonic Anhydrase IX; Carbonic anhydrase 9; Carbonate dehydratase IX; CAIX; Membrane antigen MN; P54/58N; Renal cell carcinoma-associated antigen G4-250; pMW1; G4-250; MN; CA9 clia kit
Reactivity
Human
Specificity
The LumiAb Human BMP-2 ELISA is capable of recognizing both recombinant and naturally produced Human BMP-2 proteins. The antigens listed below were tested at 50 ng/ml and exhibited less than 10% cross reactivity.
Sequence Length
459
Assay Type
Quantitative Sandwich
Sensitivity
8 pg/ml.
Preparation and Storage
Store at 4 degree C for 6 months.
Related Product Information for CA9 clia kit
Principle of the Assay: The LumiAb Human BMP-2 Chemiluminescent ELISA Kit contains the components necessary for quantitative determination of natural or recombinant Human BMP-2 concentrations within any experimental sample including cell lysates, serum and plasma. This particular immunoassay utilizes the quantitative technique of a "Sandwich" Enzyme-Linked Immunosorbent Assay (ELISA) where the target protein (antigen) is bound in a "sandwich" format by the primary capture antibodies coated to each well-bottom and the secondary detection antibodies added subsequently by the investigator. The capture antibodies coated to the bottom of each well are specific for a particular epitope on Human BMP-2 while the user-added detection antibodies bind to epitopes on the captured target protein. Amid each step of the procedure, a series of wash steps must be performed to ensure the elimination of non-specific binding between proteins to other proteins or to the solid phase. After incubation and "sandwiching" of the target antigen, a peroxidase enzyme is conjugated to the constant heavy chain of the secondary antibody (either covalently or via Avidin/Streptavidin-Biotin interactions), allowing for a sensitive luminescent reaction to ensue upon substrate addition. When the Peroxide Enhancer solution is added, the reaction catalyzed by peroxidase yields light that is representative of the antigen concentration. After a brief incubation, the microplate can be read with a luminometer, allowing for generation of a standard curve and subsequent determination of protein concentration!!Background/Introduction: Human BMP-2, also known as Bone Morphogenetic Protein 2, is a 396 amino acid cytokine protein implicated in the induction of cartilage and bone formation. The protein expressed from the BMP2 gene at locus 20p12 on chromosome 20 belongs to the Transforming Growth Factor beta (TGFbeta) superfamily. After initial translation of the peptide, it is subject to proteolytic processing and cleavage, which results in the separation of the 23 residue signal sequence from the 259 residue pro-peptide and 114 residue mature BMP-2 cytokine. The encoded protein acts as a disulfide-linked homodimer that interacts with SOSTDC1, GREM2, RGMA, RGMB, RGMC and ASPN. In terms of tissue specificity, the BMP-2 protein is particularly abundant in the lungs, spleen and colon and less abundant but still prevalent in the heart, brain, placenta, liver, skeletal muscle, kidneys, pancreas, prostate, ovaries and small intestine.
Product Categories/Family for CA9 clia kit
NCBI and Uniprot Product Information
NCBI GI #
NCBI GeneID
UniProt Accession #
NCBI Official Full Name
carbonic anhydrase IX
NCBI Official Synonym Full Names
carbonic anhydrase 9
NCBI Official Symbol
CA9
NCBI Official Synonym Symbols
MN; CAIX
NCBI Protein Information
carbonic anhydrase 9
UniProt Protein Name
Carbonic anhydrase 9
UniProt Gene Name
CA9
UniProt Synonym Gene Names
G250; MN; CA-IX; CAIX; RCC-associated antigen G250
Customer Reviews
Loading reviews...
Share Your Experience
Similar Products
Product Notes
The Human CA9 ca9 (Catalog #AAA318601) is a CLIA Kit and is intended for research purposes only. The product is available for immediate purchase. The AAA318601 CLIA Kit recognizes Human CA9. It is sometimes possible for the material contained within the vial of "Carbonic Anhydrase IX, CLIA Kit" to become dispersed throughout the inside of the vial, particularly around the seal of said vial, during shipment and storage. We always suggest centrifuging these vials to consolidate all of the liquid away from the lid and to the bottom of the vial prior to opening. Please be advised that certain products may require dry ice for shipping and that, if this is the case, an additional dry ice fee may also be required.Precautions
All products in the AAA Biotech catalog are strictly for research-use only, and are absolutely not suitable for use in any sort of medical, therapeutic, prophylactic, in-vivo, or diagnostic capacity. By purchasing a product from AAA Biotech, you are explicitly certifying that said products will be properly tested and used in line with industry standard. AAA Biotech and its authorized distribution partners reserve the right to refuse to fulfill any order if we have any indication that a purchaser may be intending to use a product outside of our accepted criteria.Disclaimer
Though we do strive to guarantee the information represented in this datasheet, AAA Biotech cannot be held responsible for any oversights or imprecisions. AAA Biotech reserves the right to adjust any aspect of this datasheet at any time and without notice. It is the responsibility of the customer to inform AAA Biotech of any product performance issues observed or experienced within 30 days of receipt of said product. To see additional details on this or any of our other policies, please see our Terms & Conditions page.Item has been added to Shopping Cart
If you are ready to order, navigate to Shopping Cart and get ready to checkout.